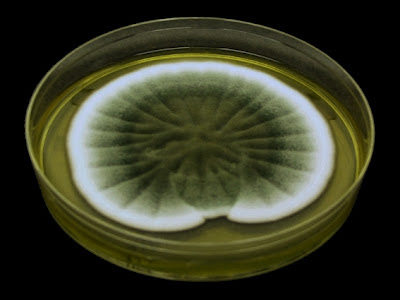

Aspergillus sydowii(Fungus)
Distribution: Worldwide distribution however may occur with increased frequency between 26o– 35o latitudes. Primarily found in soils but has been recovered from a variety of sources, both indoor and outdoor.
Pathogenicity:Implicated as an agent of invasive aspergillosis, keratomycosis (infection of cornea/eye), and onychomycosis (nail infection).
Aspergillus sydowii SAB 10 Days
Macroscopic Morphology: Growth rate is moderate. Colour is influenced by media. It has been described as a blue-green to dark green to greyish-turquoise. Colonies may have straw-coloured to reddish-brown shades with exudate. Reverse is usually maroon, reddish, to reddish-brown. The isolate presented here was grown on SAB media and appears dark green with a white fringe. Texture has been described as lanose (woolly), velutinous (dense, silky hairy) or floccose (tufts of hair/hairy). All the preceding means is that A.sydowii produces rather long conidiophore stipes (~stems) up to 200 µm which can give the colony that woolly or hairy appearance.
Micsroscopic Morphology: The long, smooth-walled stipes which bear the conidiophores are hyaline generally (translucent/transparent/colourless) or slightly brownish. The vesicles (7.0 µm - 17 µm wide) may appear sub-spherical, pyriform (pear or teardrop shaped) to somewhat clavate (club shaped). Conidiogenous structures are biserate with metulae[1](2 µm -3.5 µm by 4 µm -6 µm) and phialides (2 µm – 3 µm by 5 µm – 7 µm) in size. Diminutive conidial structures are produced by many isolates which may resemble penicillate (like Penicillium) heads. Conidia are spherical, echinulate or spinose (rough, jagged texture), and are about 2.5 µm to 4.0 µm in diameter. Hülle cells may be present.
Note: All photos below were taken with the Leica DMD-108 digital microscope. The optical magnification is recorded, however, if a +10 appears after the optical magnification factor, it denotes an additional 10% digital magnification.
Note: All photos below were taken with the Leica DMD-108 digital microscope. The optical magnification is recorded, however, if a +10 appears after the optical magnification factor, it denotes an additional 10% digital magnification.
Aspergillus sydowii -Slide Culture 48 hrs (X250 LPCB)
A.sydowii - Adhesive Tape Preparation (X1000 LPCB)
Aspergillus sydowii (X1000 LPCB)
Vesicle with biserate conidiogenous structures
Ditto
Aspergillus sydowii - Adhesive Tape Preparation (X1000+10 LPCB)
Vesicle bearing conidiogenous metulae & phailides (biserate)
A.sydowii (X1000 LPCB)
(Note 100 µm bar at upper right)
As above -another view (X1000+10 LPCB)
A.sydowii -Yet another view - As above
A.sydowii (X1000+10 LPCB)
(Note echinulate or spinose [rough] surface texture of conidia)
Aspergillus sydowii (X1000 LPCB)
Aspergillus sydowii - Long Stipes (X1000 LPCB)
A.sydowii - Adhesive Tape Preparation (X1000 LPCB)
(Note reduced conidiophore structure resembling Penicillium species)
A.sydowii conidia (X1000+10 LPCB)
(Note echinulate or spinose [rough] surface texture of conidia)
Note: They may be distinguished from Aspergillus versicolor by their turquoise colony hue if grown on CYA25 agar. The moderately growing A.sydowiiproduces rather small colonies within a week compared to many other Aspergillus species. The rough conidia borne from small, compact biserate conidial heads on hyaline to slightly brown stipes is also distinctive.